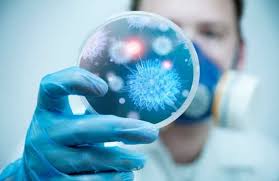
تعرف على الأمراض المداية المُهملة

في يومها العالمي الأول.. تعرف على الأمراض المدارية المهملة
مع إحياء اليوم العالمي الأول 30 يناير، الموافق اليوم، الخميس، للأمراض المدارية المُهملة التي تتمثل في الديدان الطفيلية والجراثيم والحمى الفيروسية التي تؤثر على حياة أكثر من 1,5 مليار شخص في البلدان النامية والأشد فقرًا في العالم، نرصد لكم أهم المعلومات عن هذه الأمراض.
ووفقًا لموقع healthline تنتشر الأمراض المدارية المُهملة ومنها:
- الجذام
-الكوليرا
-الحمى الصفراء
-التهاب الدماغ
ويسلط الضوء اليوم على هذه الأمراض المدارية التي تتواجد بشكل كبير في دول النامية والفقيرة والتي تؤثر على صحة الكثير من الأفراد، فبرغم من التقدم الكبير الذي تحقق في السنوات الماضية لكن ما زالت هذه الأمراض تؤثر بشكل كبير على صحة الإنسان.




















